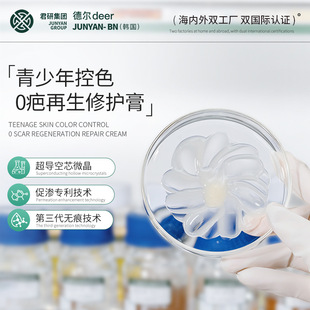
�n�������������ɫ0���������o�������������|ȥ��ӡ�ޏ���˪

-
共78張
韓國再生霜
圖片
-
半永久紋綉用品韓國CS再生霜修復劑精華紋眉紋寶修復霜紋綉修復膏圖片
-
韓國本土Rejuall rejuveon PDRN修復面舒緩再生霜術后敏感肌20g圖片
-
韓國花紋修護蜜再生霜 紋綉修復劑紋眉護理液零結痂鎖色精華100包
-
韓國本土Rejuall rejuveon PDRN修復面舒緩再生霜術后敏感肌20g
-
韓國 CS再生霜再 生膏術后修復霜半修復膏紋綉修復劑耗材修復冰晶
-
半永久紋綉用品韓國CS再生霜修復劑精華紋眉紋寶修復霜紋綉修復膏
-
韓國CS再生霜 半永久紋綉修復劑精華紋眉紋寶修復霜紋綉修復膏
-
韓國本土Rejuall rejuveon PDRN修復面舒緩再生霜術后敏感肌20g
-
韓式半永久再生霜 CS紋眉術后恢復美妝工具 韓式紋綉修飾劑
-
韓式半永久再生霜 韓式紋綉修飾劑CS紋眉術后恢復美妝工具
-
半永久紋綉修復膏韓國CS修護霜修復劑精華紋寶紋眉修復霜紋綉用品
-
半永久紋綉修復膏韓國CS修護霜修復劑精華紋寶紋眉修復霜紋綉用品
-
韓式半永久再生霜 韓式紋綉修護劑CS紋眉術后恢復美妝工具
-
半永久紋綉用品韓國CS修護霜修復劑精華紋眉紋寶修復霜紋綉修復膏
-
跨境專供Rejuveon韓國PDRN護膚品20克強化抗皺亮膚面霜現貨批發
-
韓式半永久再生霜 韓式紋綉修護劑CS紋眉術后恢復美妝工具
-
韓國SOVONN面部修護霜40ml再生霜保濕和低氧化光滑肌積雪草修復霜
-
韓國本土Rejuall rejuveon PDRN修復面舒緩再生霜術后敏感肌20g
-
韓國原裝半永久紋綉眉眼唇術后CELL再生膏修復霜 修復膏 修復乳
-
韓國花色固色紋眉再生修復膏紋綉霜紋眉部修復劑紋綉品再生修復霜
-
韓國花色固色紋眉再生修復膏紋綉霜紋眉部修復劑紋綉品再生修復霜
-
韓國花色固色紋眉再生修復膏紋綉霜紋眉部修復劑紋綉品再生修復霜
-
韓國花色固色紋眉再生修復膏紋綉霜部修復劑紋綉品修復霜美容
-
正品韓國花紋修護蜜cs再生霜紋綉修復劑紋眉護理液零結痂鎖色精華
-
半永久紋綉用品韓國CS修護霜修復劑精華紋眉紋寶修復霜紋綉修復膏
-
再生膏修復霜韓國原裝半永久紋綉眉眼唇術后CELL修復膏修復乳
-
跨境Rejuall rejuveon PDRN修護面亢皺美bai舒緩再生霜三文魚20g
-
紋綉修護眉毛修復劑紋身紋眉唇修復液膏半永久精華固色護膚美容
-
跨境Rejuall rejuveon PDRN修護面亢皺美bai舒緩再生霜三文魚20g
-
韓式半永久再生霜韓式紋綉修護劑CS紋眉術后修護色乳修護劑修護乳
-
跨境Rejuall rejuveon PDRN修護面扛皺美bai再生霜三文魚20g保濕
-
跨境Rejuall rejuveon PDRN修護面霜美bai舒緩再生霜三文魚20g
阿里巴巴為您找到約78張韓國再生霜圖片,阿里巴巴的韓國再生霜圖片大全擁有海量精選高清圖片,大量的細節圖,多角度拍攝,全方位真人展示,為您購買韓國再生霜相關產品提供全方位的圖片參考。您還可以找等相關產品圖片信息。 移動版:韓國再生霜圖片